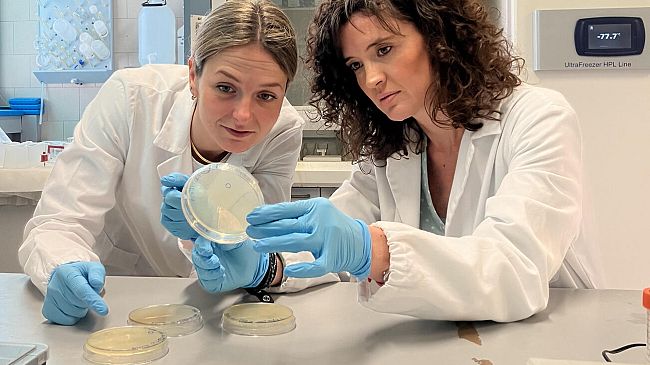
Cosa succede al cervello durante il digiuno?

Molte persone ricorrono al digiuno spinte dalla moda o dalla pubblicità. Mentre alcuni effetti positivi del digiuno sulla longevità sono noti, non conosciamo cosa accade precisamente alle cellule del nostro cervello in conseguenza di uno scarso apporto di cibo. Uno studio coordinato da Paola Tognini, ricercatrice del dipartimento di Ricerca traslazionale dell’Università di Pisa (Unità di Fisiologia), ha dimostrato che l’assenza di cibo provoca alterazioni nell’espressione genica della corteccia cerebrale, andando a influire in particolare sull’orologio biologico.
I risultati della ricerca, pubblicati in un articolo sulla rivista del gruppo Springer-Nature “Cellular and Molecular Life Sciences”, sono frutto di una collaborazione tra Università di Pisa, University of California Irvine (Stati Uniti), Scuola Normale Superiore, Istituto di Neuroscienze e Istituto di fisiologia clinica del Consiglio nazionale delle ricerche (Cnr-Ifc) e IRCCS Fondazione Stella Maris.
Il team di ricercatori ha dimostrato come il beta-idrossibutirrato, un corpo chetonico prodotto dal nostro organismo durante le condizioni di digiuno, abbia la capacità di alterare la cromatina e l’espressione genica nella corteccia cerebrale: “L’assenza di cibo rappresenta uno stimolo stressante per il nostro organismo, il quale si trova a dover rispondere alle richieste energetiche di un gran numero di tessuti – spiega Paola Tognini – Il glucosio non è più sufficiente, e il nostro corpo comincia a produrre corpi chetonici come fonte energetica alternativa.
Il beta-idrossibutirrato è il principale corpo chetonico che raggiunge il cervello durante periodi di digiuno. In passato si pensava che il cervello usasse il beta-idrossibutirrato solo come substrato per produrre energia. In collaborazione con i laboratori di metabolomica della dott.ssa Amalia Gastaldelli e di proteomica della dott.ssa Silvia Rocchiccioli di Cnr-Ifc abbiamo utilizzato le tecniche di spettrometria di massa ad alta risoluzione per misurare le concentrazioni di beta-idrossibutirrato nel fegato (dove viene principalmente prodotto), nel plasma (dove viene rilasciato) e nel cervello scoprendo che le cellule cerebrali sfruttano il beta-idrossibutirrato anche come donatore chimico, causando alterazioni nella struttura di proteine, in particolare proteine che si trovano nel nucleo delle cellule e che sono in contatto con il DNA (la cosiddetta cromatina).
In conseguenza di ciò, abbiamo scoperto drammatici cambiamenti nell’espressione genica del cervello”.
I ricercatori hanno osservato che i principali cambiamenti nell’espressione dei geni riguardano l’orologio circadiano, che rappresenta un sistema per regolare i processi biologici in sincronia con l’alternanza del giorno e della notte lungo le 24 ore. “I nostri esperimenti hanno dimostrato che non solo i livelli dei geni dell’orologio vengono alterati – aggiunge Sara Cornuti, dottoranda della Scuola Normale Superiore e prima autrice dell’articolo – ma anche l’attività locomotoria subisce dei cambiamenti. È stato inoltre verificato che queste variazioni di ritmo circadiano si mantengono anche dopo la reintroduzione del cibo, suggerendo l’esistenza di una traccia di memoria nei circuiti implicati nel controllo di tali ritmi”.
Dimostrando come il digiuno sia un potente regolatore dei livelli di espressione genica nel sistema nervoso centrale, questa nuova ricerca apre nuove frontiere per l’utilizzo della nutrizione o dei supplementi alimentari come strategie alternative o adiuvanti per il trattamento di disturbi del neurosviluppo o neuropsichiatrici.